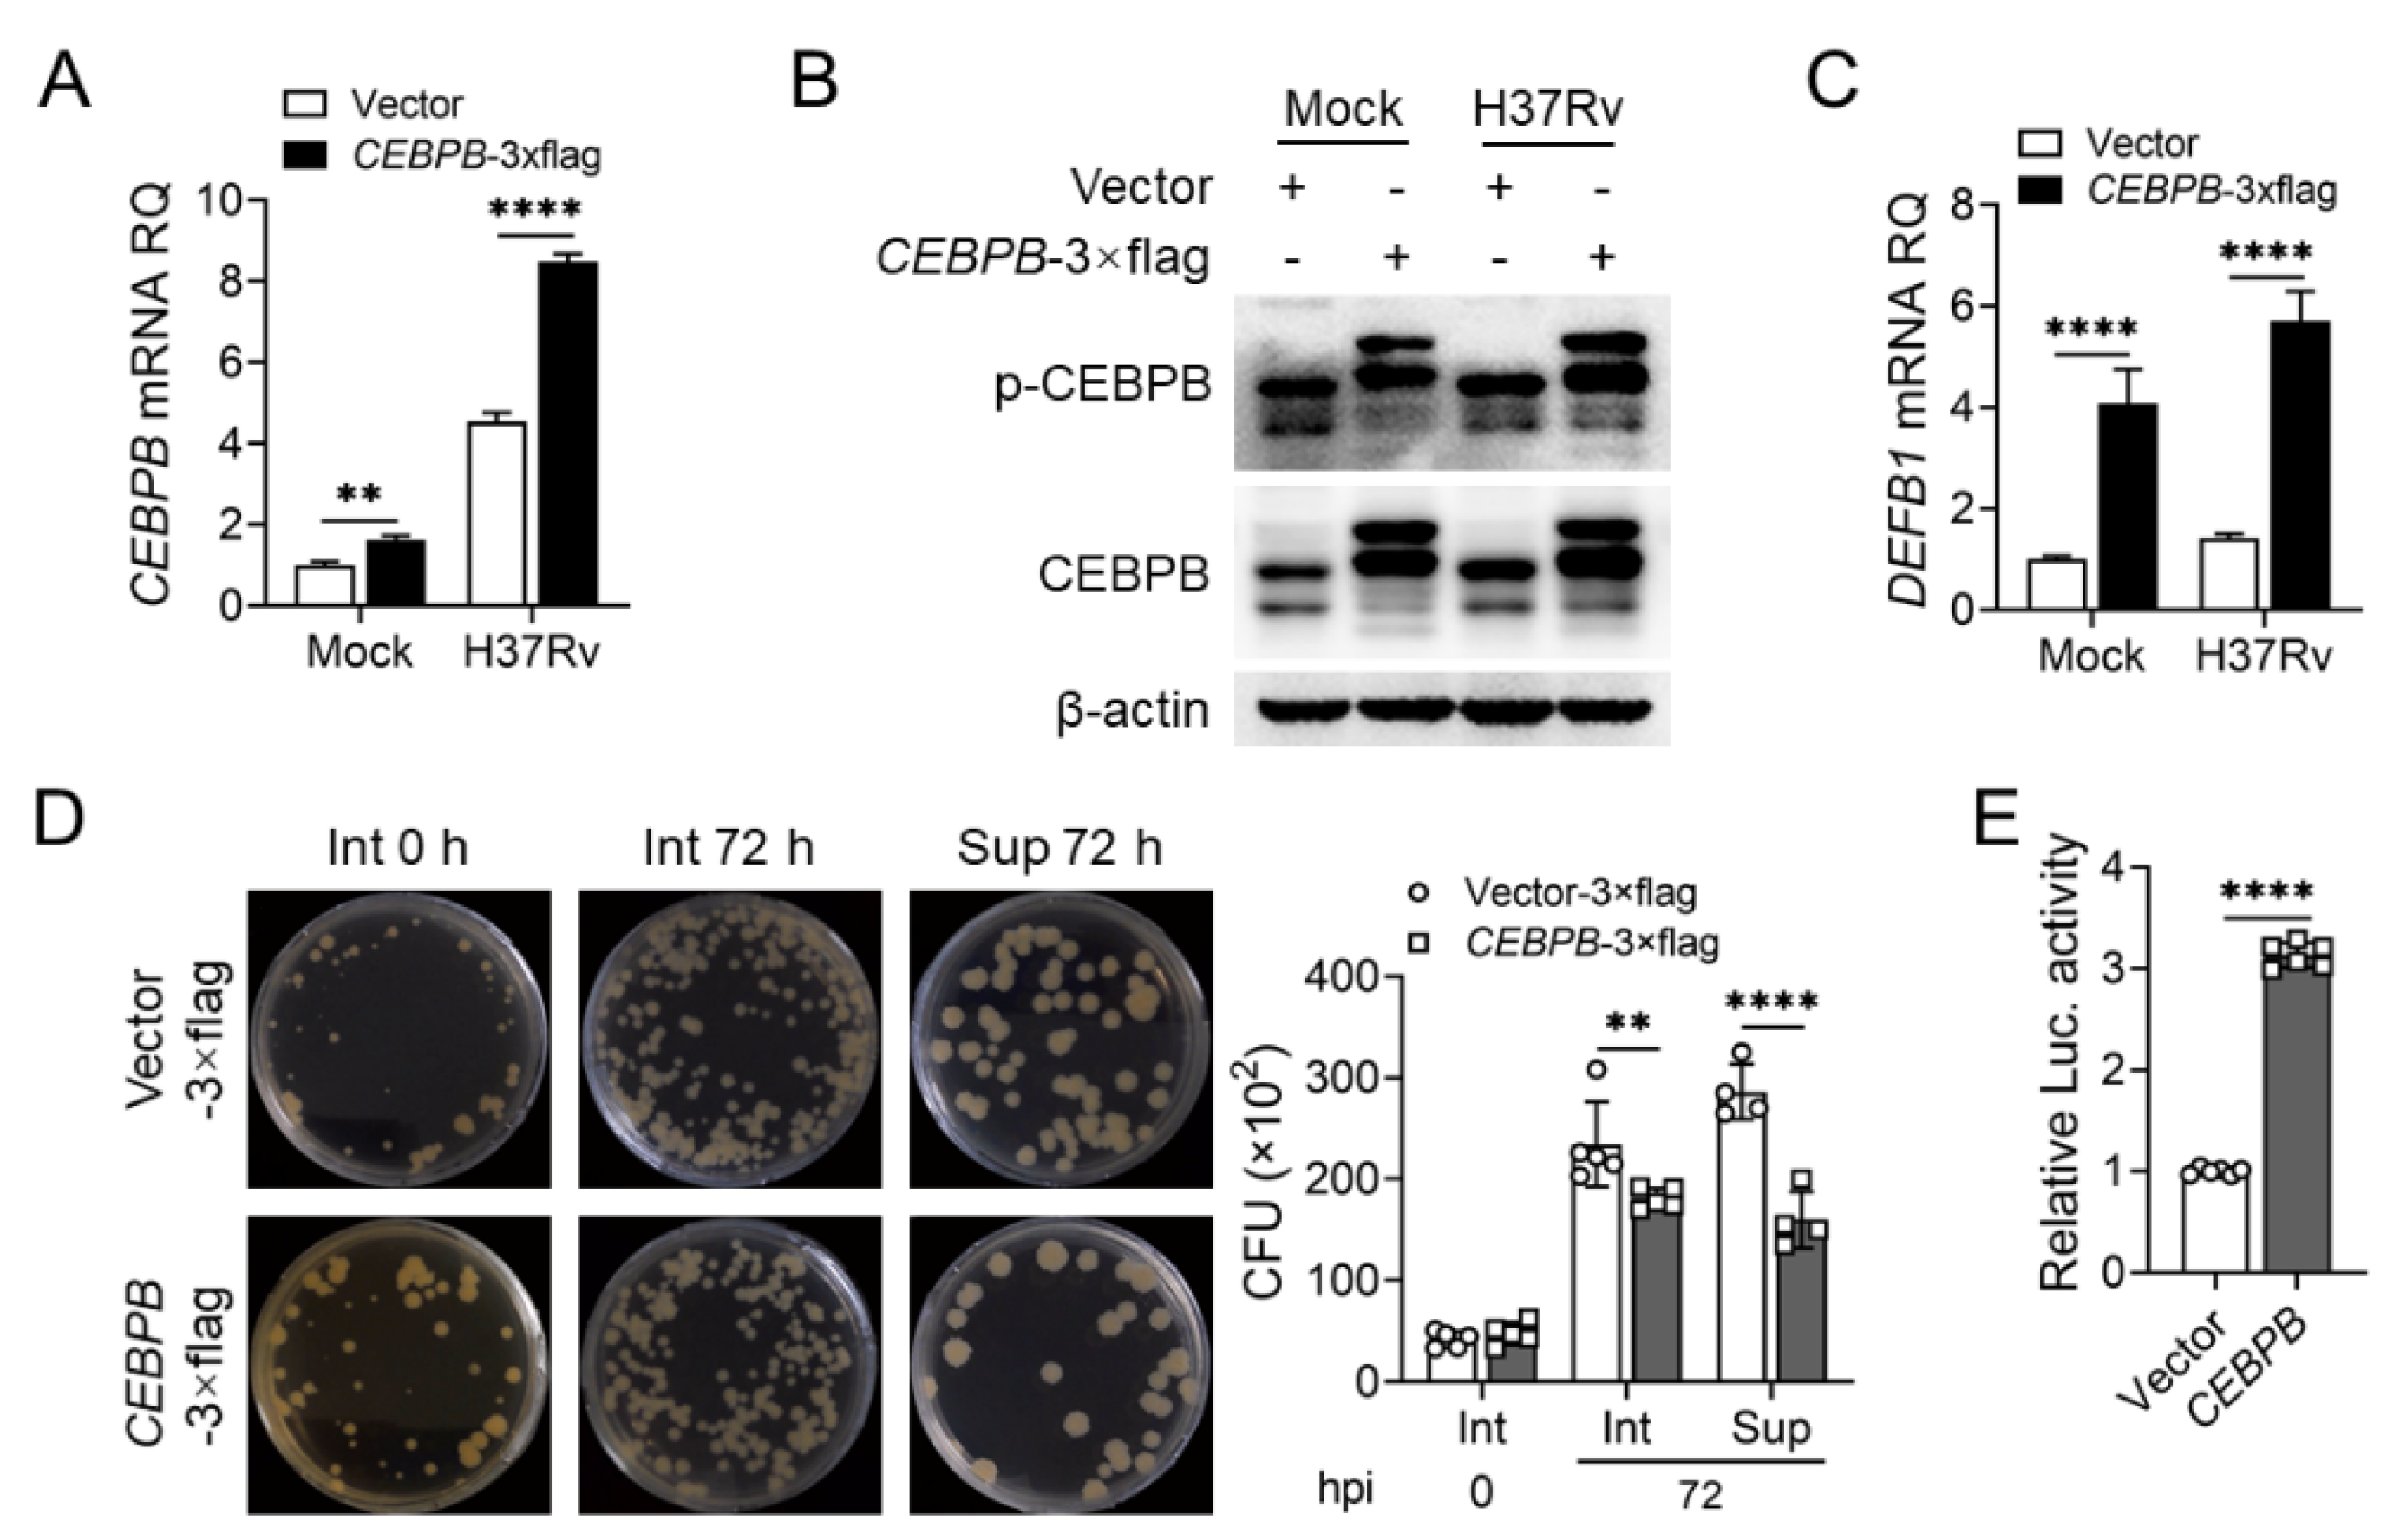
Ijms 25 02408 g006

ERK1/2-CEBPB Axis-Regulated hBD1 Enhances Anti-Tuberculosis Capacity in Alveolar Type II Epithelial Cells
Abstract
1. Introduction
2. Results
2.1. HBD1 Effectively Inhibits the Proliferation of Mtb In Vitro in AEC-II Cells and In Vivo
2.2. Transcription Factor Prediction for the Regulation of hBD1 Expression
2.3. STAT1 Downregulates DEFB1 Expression in AEC-II Cells
2.4. CEBPB Promotes DEFB1 Expression in AEC-II Cells
2.5. Identification of CEBPB Binding Sites on the DEFB1 Promoter
2.6. The ERK1/2 Pathway Regulates CEBPB Phosphorylation and in Turn DEFB1 Expression
3. Discussion
4. Materials and Methods
4.1. Cells, Mice, and Agents
4.2. Mtb Culture, Infection, and Colony-Forming Unit Assay (CFU)
4.3. RNA Extraction, Quantitative Real-Time PCR, and High-Throughput RNA Sequencing
4.4. Recombinant Plasmid Construction and Nucleic Acid Transfection
4.5. Animal Experiments
4.6. Western Blotting and Subcellular Fractionation
4.7. Luciferase Reporter Assay
4.8. Chromatin Immunoprecipitation (ChIP)
4.9. Statistical Analysis
Supplementary Materials
Author Contributions
Funding
Institutional Review Board Statement
Informed Consent Statement
Data Availability Statement
Conflicts of Interest
References
- Bagcchi, S. WHO’s global tuberculosis report 2022. Lancet Microbe 2023, 4, e20. [Google Scholar] [CrossRef]
- Cambier, C.J.; Falkow, S.; Ramakrishnan, L. Host evasion and exploitation schemes of Mycobacterium tuberculosis. Cell 2014, 159, 1497–1509. [Google Scholar] [CrossRef]
- Yang, Q.; Zhang, M.; Chen, Q.; Chen, W.; Wei, C.; Qiao, K.; Ye, T.; Deng, G.; Li, J.; Zhu, J.; et al. Cutting edge: Characterization of human tissue-resident memory T cells at different infection sites in patients with tuberculosis. J. Immunol. 2020, 204, 2331–2336. [Google Scholar] [CrossRef]
- Chrétien, J.; Basset, F.; Jaubert, F.; Soler, P.; Danel, C. Cellular biology and pathology of type II pneumocytes. Int. Arch. Allergy Appl. Immunol. 1985, 76 (Suppl. 1), 49–61. [Google Scholar] [CrossRef]
- Leiby, K.L.; Yuan, Y.; Ng, R.; Raredon, M.S.B.; Adams, T.S.; Baevova, P.; Greaney, A.M.; Hirschi, K.K.; Campbell, S.G.; Kaminski, N.; et al. Rational engineering of lung alveolar epithelium. Npj Regen. Med. 2023, 8, 22. [Google Scholar] [CrossRef]
- Rohmann, K.; Tschernig, T.; Pabst, R.; Goldmann, T.; Drömann, D. Innate immunity in the human lung: Pathogen recognition and lung disease. Cell Tissue Res. 2011, 343, 167–174. [Google Scholar] [CrossRef]
- Schmiedl, A.; Kerber-Momot, T.; Munder, A.; Pabst, R.; Tschernig, T. Bacterial distribution in lung parenchyma early after pulmonary infection with Pseudomonas aeruginosa. Cell Tissue Res. 2010, 342, 67–73. [Google Scholar] [CrossRef]
- Debbabi, H.; Ghosh, S.; Kamath, A.B.; Alt, J.; Demello, D.E.; Dunsmore, S.; Behar, S.M. Primary type II alveolar epithelial cells present microbial antigens to antigen-specific CD4+ T cells. Am. J. Physiol. Lung Cell. Mol. Physiol. 2005, 289, L274–L279. [Google Scholar] [CrossRef] [PubMed]
- Burgoyne, R.A.; Fisher, A.J.; Borthwick, L.A. The role of epithelial damage in the pulmonary immune response. Cells 2021, 10, 2763. [Google Scholar] [CrossRef] [PubMed]
- Li, Z.; Lu, G.; Meng, G. Pathogenic fungal infection in the lung. Front. Immunol. 2019, 10, 1524. [Google Scholar] [CrossRef] [PubMed]
- Jacobo-Delgado, Y.M.; Torres-Juarez, F.; Rodríguez-Carlos, A.; Santos-Mena, A.; Enciso-Moreno, J.E.; Rivas-Santiago, C.; Diamond, G.; Rivas-Santiago, B.; Alonso-Macias, J.; Deharo-Acosta, J.; et al. Retinoic acid induces antimicrobial peptides and cytokines leading to Mycobacterium tuberculosis elimination in airway epithelial cells. Peptides 2021, 142, 170580. [Google Scholar] [CrossRef]
- Mahlapuu, M.; Björn, C.; Ekblom, J. Antimicrobial peptides as therapeutic agents: Opportunities and challenges. Crit. Rev. Biotechnol. 2020, 40, 978–992. [Google Scholar] [CrossRef] [PubMed]
- Ambrosio, R.L.; Rosselló, C.A.; Casares, D.; Palmieri, G.; Anastasio, A.; Escribá, P.V. The antimicrobial peptide 1018-K6 interacts distinctly with eukaryotic and bacterial membranes, the basis of its specificity and bactericidal activity. Int. J. Mol. Sci. 2022, 23, 12392. [Google Scholar] [CrossRef]
- Koo, H.B.; Seo, J. Antimicrobial peptides under clinical investigation. Pept. Sci. 2019, 111, e24122. [Google Scholar] [CrossRef]
- Liebenberg, D.; Gordhan, B.G.; Kana, B.D. Drug resistant tuberculosis: Implications for transmission, diagnosis, and disease management. Front. Cell. Infect. Microbiol. 2022, 12, 943545. [Google Scholar] [CrossRef]
- AlMatar, M.; Makky, E.A.; Yakıcı, G.; Var, I.; Kayar, B.; Köksal, F. Antimicrobial peptides as an alternative to anti-tuberculosis drugs. Pharmacol. Res. 2018, 128, 288–305. [Google Scholar] [CrossRef]
- Rekha, R.S.; Rao Muvva, S.S.; Wan, M.; Raqib, R.; Bergman, P.; Brighenti, S.; Gudmundsson, G.H.; Agerberth, B. Phenylbutyrate induces LL-37-dependent autophagy and intracellular killing of Mycobacterium tuberculosis in human macrophages. Autophagy 2015, 11, 1688–1699. [Google Scholar] [CrossRef]
- Kling, A.; Lukat, P.; Almeida, D.V.; Bauer, A.; Fontaine, E.; Sordello, S.; Zaburannyi, N.; Herrmann, J.; Wenzel, S.C.; König, C.; et al. Antibiotics. Targeting DnaN for tuberculosis therapy using novel griselimycins. Science 2015, 348, 1106–1112. [Google Scholar] [CrossRef]
- Ganz, T. Defensins: Antimicrobial peptides of innate immunity. Nat. Rev. Immunol. 2003, 3, 710–720. [Google Scholar] [CrossRef]
- Mansour, B.; Monyók, Á.; Gajdács, M.; Stercz, B.; Makra, N.; Pénzes, K.; Vadnay, I.; Szabó, D.; Ostorházi, E. Bladder tissue microbiome composition in patients of bladder cancer or benign prostatic hyperplasia and related human beta defensin levels. Biomedicines 2022, 10, 1758. [Google Scholar] [CrossRef]
- Valore, E.V.; Park, C.H.; Quayle, A.J.; Wiles, K.R.; McCray, P.B., Jr.; Ganz, T. Human beta-defensin-1: An antimicrobial peptide of urogenital tissues. J. Clin. Investig. 1998, 101, 1633–1642. [Google Scholar] [CrossRef]
- Trend, S.; Strunk, T.; Lloyd, M.L.; Kok, C.H.; Metcalfe, J.; Geddes, D.T.; Lai, C.T.; Richmond, P.; Doherty, D.A.; Simmer, K.; et al. Levels of innate immune factors in preterm and term mothers’ breast milk during the 1st month postpartum. Br. J. Nutr. 2016, 115, 1178–1193. [Google Scholar] [CrossRef]
- Chen, X.; Niyonsaba, F.; Ushio, H.; Okuda, D.; Nagaoka, I.; Ikeda, S.; Okumura, K.; Ogawa, H. Synergistic effect of antibacterial agents human beta-defensins, cathelicidin LL-37 and lysozyme against Staphylococcus aureus and Escherichia coli. J. Dermatol. Sci. 2005, 40, 123–132. [Google Scholar] [CrossRef]
- Goldman, M.J.; Anderson, G.M.; Stolzenberg, E.D.; Kari, U.P.; Zasloff, M.; Wilson, J.M. Human beta-defensin-1 is a salt-sensitive antibiotic in lung that is inactivated in cystic fibrosis. Cell 1997, 88, 553–560. [Google Scholar] [CrossRef]
- Fattorini, L.; Gennaro, R.; Zanetti, M.; Tan, D.; Brunori, L.; Giannoni, F.; Pardini, M.; Orefici, G. In vitro activity of protegrin-1 and beta-defensin-1, alone and in combination with isoniazid, against Mycobacterium tuberculosis. Peptides 2004, 25, 1075–1077. [Google Scholar] [CrossRef] [PubMed]
- Sharma, R.; Saikia, U.N.; Sharma, S.; Verma, I. Activity of human beta defensin-1 and its motif against active and dormant Mycobacterium tuberculosis. Appl. Microbiol. Biotechnol. 2017, 101, 7239–7248. [Google Scholar] [CrossRef]
- Linn, O.; Menges, B.; Lammert, F.; Weber, S.N.; Krawczyk, M. Altered expression of antimicrobial peptides in the upper gastrointestinal tract of patients with diabetes mellitus. Nutrients 2023, 15, 754. [Google Scholar] [CrossRef] [PubMed]
- Lombardo Bedran, T.B.; Feghali, K.; Zhao, L.; Palomari Spolidorio, D.M.; Grenier, D. Green tea extract and its major constituent, epigallocatechin-3-gallate, induce epithelial beta-defensin secretion and prevent beta-defensin degradation by Porphyromonas gingivalis. J. Periodontal Res. 2014, 49, 615–623. [Google Scholar] [CrossRef] [PubMed]
- Bonamy, C.; Sechet, E.; Amiot, A.; Alam, A.; Mourez, M.; Fraisse, L.; Sansonetti, P.J.; Sperandio, B. Expression of the human antimicrobial peptide β-defensin-1 is repressed by the EGFR-ERK-MYC axis in colonic epithelial cells. Sci. Rep. 2018, 8, 18043. [Google Scholar] [CrossRef] [PubMed]
- Bose, S.K.; Gibson, W.; Bullard, R.S.; Donald, C.D. PAX2 oncogene negatively regulates the expression of the host defense peptide human beta defensin-1 in prostate cancer. Mol. Immunol. 2009, 46, 1140–1148. [Google Scholar] [CrossRef] [PubMed]
- Maertzdorf, J.; Tönnies, M.; Lozza, L.; Schommer-Leitner, S.; Mollenkopf, H.; Bauer, T.T.; Kaufmann, S.H.E. Mycobacterium tuberculosis Invasion of the Human Lung: First Contact. Front. Immunol. 2018, 9, 1346. [Google Scholar] [CrossRef]
- Morrison, G.M.; Davidson, D.J.; Kilanowski, F.M.; Borthwick, D.W.; Crook, K.; Maxwell, A.I.; Govan, J.R.; Dorin, J.R. Mouse beta defensin-1 is a functional homolog of human beta defensin-1. Mamm. Genome 1998, 9, 453–457. [Google Scholar] [CrossRef]
- Sun, C.Q.; Arnold, R.S.; Hsieh, C.L.; Dorin, J.R.; Lian, F.; Li, Z.; Petros, J.A. Discovery and mechanisms of host defense to oncogenesis: Targeting the β-defensin-1 peptide as a natural tumor inhibitor. Cancer Biol. Ther. 2019, 20, 774–786. [Google Scholar] [CrossRef]
- Presicce, P.; Giannelli, S.; Taddeo, A.; Villa, M.L.; Della Bella, S. Human defensins activate monocyte-derived dendritic cells, promote the production of proinflammatory cytokines, and up-regulate the surface expression of CD91. J. Leukoc. Biol. 2009, 86, 941–948. [Google Scholar] [CrossRef]
- Ginestet, C. ggplot2: Elegant graphics for data analysis. J. R. Stat. Soc. Ser. A Stat. Soc. 2011, 174, 245–246. [Google Scholar] [CrossRef]
- Bénard, A.; Sakwa, I.; Schierloh, P.; Colom, A.; Mercier, I.; Tailleux, L.; Jouneau, L.; Boudinot, P.; Al-Saati, T.; Lang, R.; et al. B cells producing type i IFN modulate macrophage polarization in tuberculosis. Am. J. Respir. Crit. Care Med. 2018, 197, 801–813. [Google Scholar] [CrossRef]
- Zhou, C.; Liang, T.; Jiang, J.; Chen, J.; Chen, T.; Huang, S.; Chen, L.; Sun, X.; Chen, W.; Zhu, J.; et al. MMP9 and STAT1 are biomarkers of the change in immune infiltration after anti-tuberculosis therapy, and the immune status can identify patients with spinal tuberculosis. Int. Immunopharmacol. 2023, 116, 109588. [Google Scholar] [CrossRef]
- Huang, D.; Bao, L. Mycobacterium tuberculosis EspB protein suppresses interferon-γ-induced autophagy in murine macrophages. J. Microbiol. Immunol. Infect. 2016, 49, 859–865. [Google Scholar] [CrossRef]
- Li, W.; Tanikawa, T.; Kryczek, I.; Xia, H.; Li, G.; Wu, K.; Wei, S.; Zhao, L.; Vatan, L.; Wen, B.; et al. Aerobic glycolysis controls myeloid-derived suppressor cells and tumor immunity via a specific CEBPB Isoform in triple-negative breast cancer. Cell Metab. 2018, 28, 87–103. [Google Scholar] [CrossRef]
- Zidek, L.M.; Ackermann, T.; Hartleben, G.; Eichwald, S.; Kortman, G.; Kiehntopf, M.; Leutz, A.; Sonenberg, N.; Wang, Z.; von Maltzahn, J.; et al. Deficiency in mTORC1-controlled C/EBPβ-mRNA translation improves metabolic health in mice. Embo Rep. 2015, 16, 1022–1036. [Google Scholar] [CrossRef] [PubMed]
- Sabir, N.; Hussain, T.; Mangi, M.H.; Zhao, D.; Zhou, X. Matrix metalloproteinases: Expression, regulation and role in the immunopathology of tuberculosis. Cell Prolif. 2019, 52, e12649. [Google Scholar] [CrossRef]
- Peng, Z.; Yue, Y.; Xiong, S. Mycobacterial PPE36 modulates host inflammation by promoting E3 ligase smurf1-mediated MyD88 degradation. Front. Immunol. 2022, 13, 690667. [Google Scholar] [CrossRef]
- Castañeda-Sánchez, J.I.; García-Pérez, B.E.; Muñoz-Duarte, A.R.; Baltierra-Uribe, S.L.; Mejia-López, H.; López-López, C.; Bautista-De Lucio, V.M.; Robles-Contreras, A.; Luna-Herrera, J. Defensin production by human limbo-corneal fibroblasts infected with mycobacteria. Pathogens 2013, 2, 13–32. [Google Scholar] [CrossRef]
- Portell-Buj, E.; Vergara, A.; Alejo, I.; López-Gavín, A.; Monté, M.R.; Nicolás, L.S.; González-Martín, J.; Tudó, G. In vitro activity of 12 antimicrobial peptides against Mycobacterium tuberculosis and Mycobacterium avium clinical isolates. J. Med. Microbiol. 2019, 68, 211–215. [Google Scholar] [CrossRef] [PubMed]
- Lerner, R.; Cuadrado, D.P.; Post, J.M.; Lutz, B.; Bindila, L. Broad Lipidomic and Transcriptional Changes of Prophylactic PEA Administration in Adult Mice. Front. Neurosci. 2019, 13, 527. [Google Scholar] [CrossRef] [PubMed]
- Rivas-Santiago, B.; Sada, E.; Tsutsumi, V.; Aguilar-León, D.; Contreras, J.L.; Hernández-Pando, R. beta-Defensin gene expression during the course of experimental tuberculosis infection. J. Infect. Dis. 2006, 194, 697–701. [Google Scholar] [CrossRef] [PubMed]
- Jacobo-Delgado, Y.M.; Rodríguez-Carlos, A.; Serrano, C.J.; Rivas-Santiago, B. Mycobacterium tuberculosis cell-wall and antimicrobial peptides: A mission impossible? Front. Immunol. 2023, 14, 1194923. [Google Scholar] [CrossRef]
- Dupuis, S.; Dargemont, C.; Fieschi, C.; Thomassin, N.; Rosenzweig, S.; Harris, J.; Holland, S.M.; Schreiber, R.D.; Casanova, J.-L. Impairment of mycobacterial but not viral immunity by a germline human STAT1 mutation. Science 2001, 293, 300–303. [Google Scholar] [CrossRef]
- Toubiana, J.; Okada, S.; Hiller, J.; Oleastro, M.; Gomez, M.L.; Becerra, J.C.A.; Ouachée-Chardin, M.; Fouyssac, F.; Girisha, K.M.; Etzioni, A.; et al. Heterozygous STAT1 gain-of-function mutations underlie an unexpectedly broad clinical phenotype. Blood 2016, 127, 3154–3164. [Google Scholar] [CrossRef] [PubMed]
- MacMicking, J.; Xie, Q.W.; Nathan, C. Nitric oxide and macrophage function. Annu. Rev. Immunol. 1997, 15, 323–350. [Google Scholar] [CrossRef] [PubMed]
- Banks, D.A.; Ahlbrand, S.E.; Hughitt, V.K.; Shah, S.; Mayer-Barber, K.D.; Vogel, S.N.; El-Sayed, N.M.; Briken, V. Mycobacterium tuberculosis inhibits autocrine type I IFN Signaling to increase intracellular survival. J. Immunol. 2019, 202, 2348–2359. [Google Scholar] [CrossRef]
- Meisch, J.P.; Vogel, R.M.; Schlatzer, D.M.; Li, X.; Chance, M.R.; Levine, A.D. Human β-defensin 3 induces STAT1 phosphorylation, tyrosine phosphatase activity, and cytokine synthesis in T cells. J. Leukoc. Biol. 2013, 94, 459–471. [Google Scholar] [CrossRef]
- de Laval, B.; Maurizio, J.; Kandalla, P.K.; Brisou, G.; Simonnet, L.; Huber, C.; Gimenez, G.; Matcovitch-Natan, O.; Reinhardt, S.; David, E.; et al. C/EBPβ-dependent epigenetic memory induces trained immunity in hematopoietic stem cells. Cell Stem Cell 2020, 26, 657–674. [Google Scholar] [CrossRef]
- Xu, Y.; Tan, Y.; Zhang, X.; Cheng, M.; Hu, J.; Liu, J.; Chen, X.; Zhu, J. Comprehensive identification of immuno-related transcriptional signature for active pulmonary tuberculosis by integrated analysis of array and single cell RNA-seq. J. Infect. 2022, 85, 534–544. [Google Scholar] [CrossRef]
- Nakajima, T.; Kinoshita, S.; Sasagawa, T.; Sasaki, K.; Naruto, M.; Kishimoto, T.; Akira, S. Phosphorylation at threonine-235 by a ras-dependent mitogen-activated protein kinase cascade is essential for transcription factor NF-IL6. Proc. Natl. Acad. Sci. USA 1993, 90, 2207–2211. [Google Scholar] [CrossRef]
- Yang, C.S.; Kim, J.J.; Lee, H.M.; Jin, H.S.; Lee, S.H.; Park, J.H.; Kim, S.J.; Kim, J.M.; Han, Y.M.; Lee, M.S.; et al. The AMPK-PPARGC1A pathway is required for antimicrobial host defense through activation of autophagy. Autophagy 2014, 10, 785–802. [Google Scholar] [CrossRef]
- Ndoja, A.; Reja, R.; Lee, S.H.; Webster, J.D.; Ngu, H.; Rose, C.M.; Kirkpatrick, D.S.; Modrusan, Z.; Chen, Y.J.J.; Dugger, D.L.; et al. Ubiquitin ligase COP1 suppresses neuroinflammation by degrading c/EBPβ in microglia. Cell 2020, 182, 1156–1169. [Google Scholar] [CrossRef]
- Chinery, R.; Brockman, J.A.; Dransfield, D.T.; Coffey, R.J. Antioxidant-induced nuclear translocation of CCAAT/enhancer-binding protein beta. A critical role for protein kinase A-mediated phosphorylation of Ser299. J. Biol. Chem. 1997, 272, 30356–30361. [Google Scholar] [CrossRef] [PubMed]
- Simpson-Abelson, M.R.; Childs, E.E.; Ferreira, M.C.; Bishu, S.; Conti, H.R.; Gaffen, S.L. C/EBPβ promotes iimmunity to oral candidiasis through regulation of β-defensins. PLoS ONE 2015, 10, e0136538. [Google Scholar] [CrossRef] [PubMed]
- Ran, F.A.; Hsu, P.D.; Wright, J.; Agarwala, V.; Scott, D.A.; Zhang, F. Genome engineering using the CRISPR-Cas9 system. Nat. Protoc. 2013, 8, 2281–2308. [Google Scholar] [CrossRef] [PubMed]
- du Sert, N.P.; Hurst, V.; Ahluwalia, A.; Alam, S.; Avey, M.T.; Baker, M.; Browne, W.J.; Clark, A.; Cuthill, I.C.; Dirnagl, U.; et al. The ARRIVE guidelines 2.0: Updated guidelines for reporting animal research. PLoS Biol. 2020, 18, e3000410. [Google Scholar] [CrossRef]
- Zhou, L.; Wang, Y.; Zhou, M.; Zhang, Y.; Wang, P.; Li, X.; Yang, J.; Wang, H.; Ding, Z. HOXA9 inhibits HIF-1α-mediated glycolysis through interacting with CRIP2 to repress cutaneous squamous cell carcinoma development. Nat. Commun. 2018, 9, 1480. [Google Scholar] [CrossRef] [PubMed]

Disclaimer/Publisher’s Note: The statements, opinions and data contained in all publications are solely those of the individual author(s) and contributor(s) and not of MDPI and/or the editor(s). MDPI and/or the editor(s) disclaim responsibility for any injury to people or property resulting from any ideas, methods, instructions or products referred to in the content. |
© 2024 by the authors. Licensee MDPI, Basel, Switzerland. This article is an open access article distributed under the terms and conditions of the Creative Commons Attribution (CC BY) license (https://creativecommons.org/licenses/by/4.0/).
Share and Cite
Chen, Y.; Han, Z.; Zhang, S.; Liu, H.; Wang, K.; Liu, J.; Liu, F.; Yu, S.; Sai, N.; Mai, H.; et al. ERK1/2-CEBPB Axis-Regulated hBD1 Enhances Anti-Tuberculosis Capacity in Alveolar Type II Epithelial Cells. Int. J. Mol. Sci. 2024, 25, 2408. https://doi.org/10.3390/ijms25042408
Chen Y, Han Z, Zhang S, Liu H, Wang K, Liu J, Liu F, Yu S, Sai N, Mai H, et al. ERK1/2-CEBPB Axis-Regulated hBD1 Enhances Anti-Tuberculosis Capacity in Alveolar Type II Epithelial Cells. International Journal of Molecular Sciences. 2024; 25(4):2408. https://doi.org/10.3390/ijms25042408
Chicago/Turabian StyleChen, Yaoxin, Zhenyu Han, Sian Zhang, Honglin Liu, Ke Wang, Jieyu Liu, Feichang Liu, Shiyun Yu, Na Sai, Haiyan Mai, and et al. 2024. "ERK1/2-CEBPB Axis-Regulated hBD1 Enhances Anti-Tuberculosis Capacity in Alveolar Type II Epithelial Cells" International Journal of Molecular Sciences 25, no. 4: 2408. https://doi.org/10.3390/ijms25042408
APA StyleChen, Y., Han, Z., Zhang, S., Liu, H., Wang, K., Liu, J., Liu, F., Yu, S., Sai, N., Mai, H., Zhou, X., Zhou, C., Wen, Q., & Ma, L. (2024). ERK1/2-CEBPB Axis-Regulated hBD1 Enhances Anti-Tuberculosis Capacity in Alveolar Type II Epithelial Cells. International Journal of Molecular Sciences, 25(4), 2408. https://doi.org/10.3390/ijms25042408

